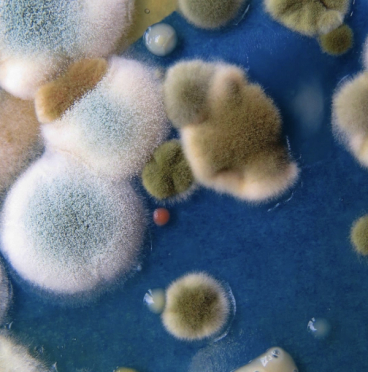
Hyfer merkevarestrategi og nettsideutvikling Nonspace

In Norway’s capital of tech and innovation, the acclaimed university, and institution of knowledge, wanted to create a festival and a platform for events and activities, where people, expertise, science and culture meet.
Highlights


























About the project
Hyfer is a Norwegian edtech company redefining how digital assessment works in modern education. Their platform enables teachers to create, distribute, and assess assignments more efficiently, combining powerful tools with a seamless user experience. With a mission to empower educators and improve learning outcomes, Hyfer is shaping the future of classroom assessment.
Aiming to stimulate exploration and discussions on contemporary research topics, we worked with the team to develop the concept, name and the identity for the festival, landing on the concept of Hyfer - a festival for the future on a mission to create synergies and collaborations across technology, innovation, art, and culture.
The festival, initiated by the renowned NTNU (Norwegian University of Science and Technology), held enormous potential but faced a challenge in making itself approachable to a broader audience. To address this issue, we needed to create a concept and a new identity that could scale up, attracting a new generation of thinkers. In collaborative workshops with our client, our mission was clear: to bridge the gap between the scientific community and a wider audience, establishing an eye-catching and distinct brand in a crowded field of events.
To create a future festival that celebrates knowledge, arts, engineering, and science, we wanted to make a name and identity that could represent the purpose of the brand. The name Hyfer is rooted in the interconnectedness of organic matter, much like how hyphae cells in mushrooms communicate valuable information through connections. We aimed to create an inviting and inclusive visual identity, combining the artistic essence of "hyfe" with the scientific aspects of the brand. The result was a visually captivating profile capable of working on multiple levels.
The visual identity replicates the growing patterns of the organic matter and how this knowledge network could grow and find new communication pathways. The colour palette is derived directly from surprisingly vibrant organic matter interpreted into a palette tailored for digital use.
The brand was designed to be flexible, covering various events and communication, combining knowledge, art, culture, and the festival spirit. Our strategy was to break away from the stereotype that knowledge and science are dry and unappealing, repositioning our client as an exciting player with a vision for the future.
We constructed a comprehensive brand strategy that included a new name, visual identity, website, and social media assets. The festival aimed to become a continual platform for content and events, ensuring that it remained an integral part of the city year-round, evolving to meet the city's changing needs.

Relevant cases
Brand, Name, Website and Pitch Deck for Strise

The Next Generation Today

Become Trondheim
